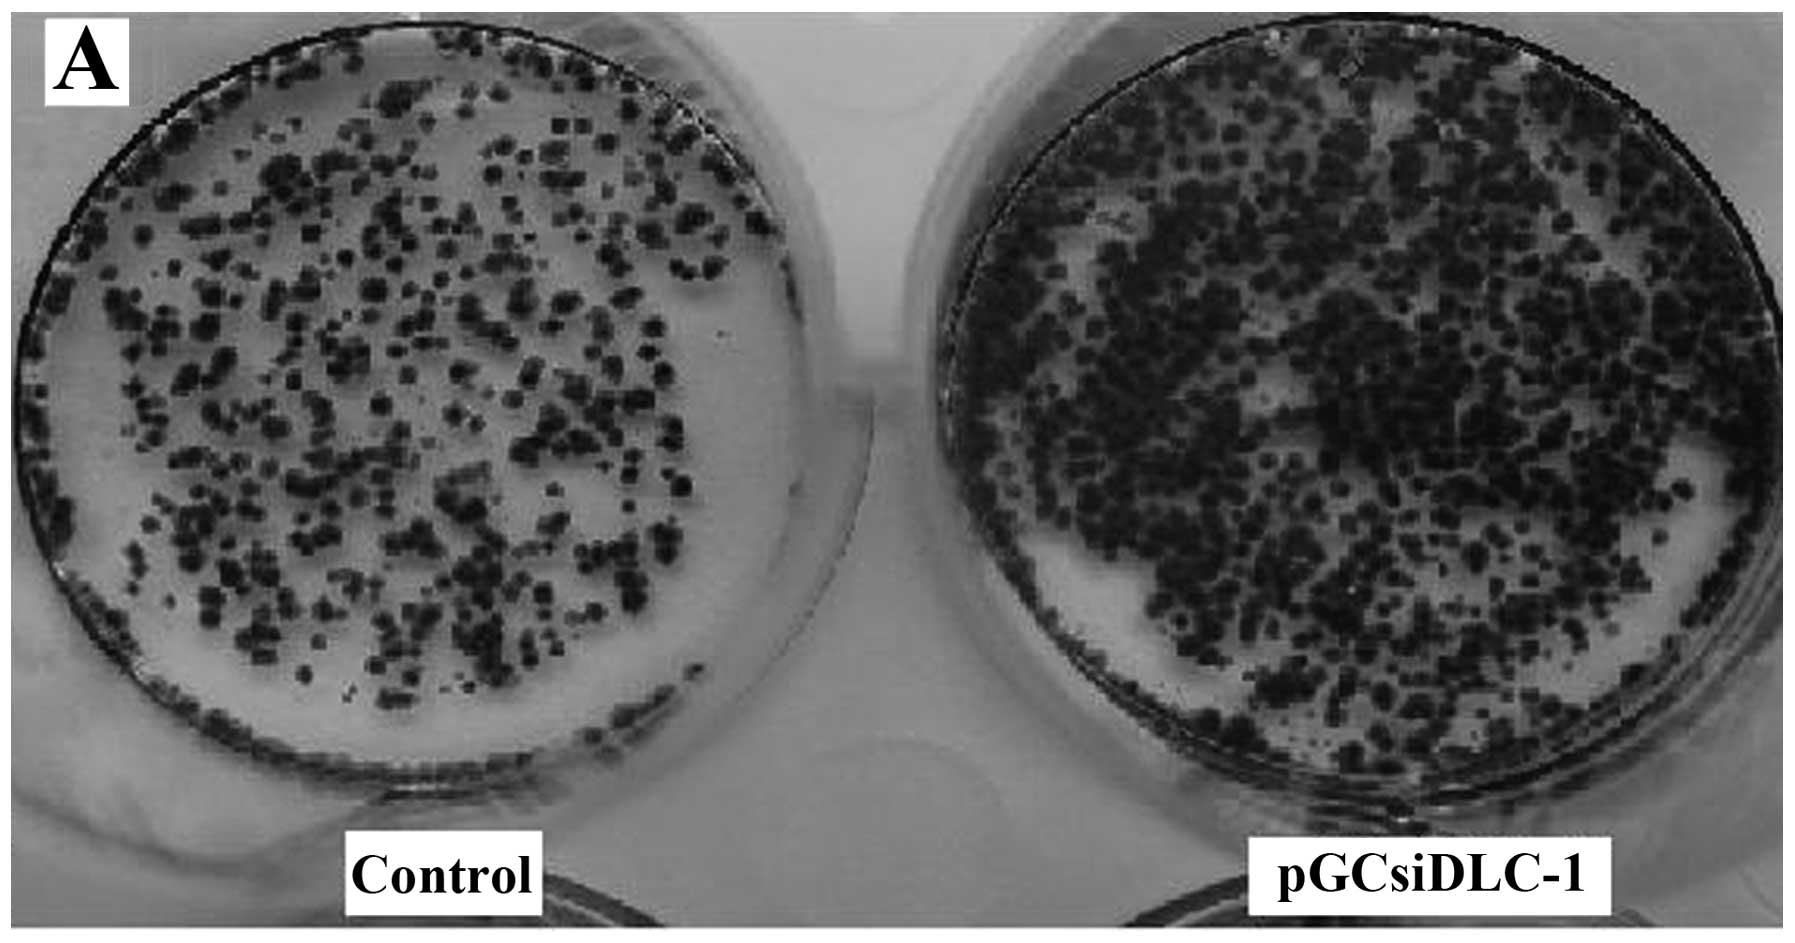

|
1
|
Zhang X, Li W, Li H, et al: Genomic
methylation profiling combined with gene expression microarray
reveals the aberrant methylation mechanism involved in
nasopharyngeal carcinoma taxol resistance. Anticancer Drugs.
23:856–864. 2012. View Article : Google Scholar
|
|
2
|
Muehlich S, Hampl V, Khalid S, et al: The
transcriptional coactivators megakaryoblastic leukemia 1/2 mediate
the effects of loss of the tumor suppressor deleted in liver cancer
1. Oncogene. 31:3913–3923. 2012. View Article : Google Scholar : PubMed/NCBI
|
|
3
|
Low JS, Tao Q, Ng KM, et al: A novel
isoform of the 8p22 tumor suppressor gene DLC1 suppresses tumor
growth and is frequently silenced in multiple common tumors.
Oncogene. 30:1923–1935. 2011. View Article : Google Scholar : PubMed/NCBI
|
|
4
|
Castro M, Grau L, Puerta P, et al:
Multiplexed methylation profiles of tumor suppressor genes and
clinical outcome in lung cancer. J Transl Med. 8:862010. View Article : Google Scholar : PubMed/NCBI
|
|
5
|
Zimonjic DB and Popescu NC: Role of DLC1
tumor suppressor gene and MYC oncogene in pathogenesis of human
hepatocellular carcinoma: Potential prospects for combined targeted
therapeutics (Review). Int J Oncol. 41:393–406. 2012.
|
|
6
|
Pang JC, Chang Q, Chung YF, et al:
Epigenetic inactivation of DLC-1 in supratentorial primitive
neuroectodermal tumor. Hum Pathol. 36:36–43. 2005. View Article : Google Scholar : PubMed/NCBI
|
|
7
|
Flanagan S, Lee M, Li CC, et al: Promoter
methylation analysis of IDH genes in human gliomas. Front Oncol.
2:1932012. View Article : Google Scholar : PubMed/NCBI
|
|
8
|
Uhm KO, Lee ES, Lee YM, et al: Aberrant
promoter CpG islands methylation of tumor suppressor genes in
cholangiocarcinoma. Oncol Res. 17:151–157. 2008. View Article : Google Scholar : PubMed/NCBI
|
|
9
|
Park SW, Durkin ME, Thorgeirsson SS and
Popescu NC: DNA variants of DLC-1, a candidate tumor suppressor
gene in human hepatocellular carcinoma. Int J Oncol. 23:133–137.
2003.PubMed/NCBI
|
|
10
|
Shi H, Guo J, Duff DJ, et al: Discovery of
novel epigenetic markers in non-Hodgkin’s lymphoma. Carcinogenesis.
28:60–70. 2007.PubMed/NCBI
|
|
11
|
Liao YC, Shih YP and Lo SH: Mutations in
the focal adhesion targeting region of deleted in liver cancer-1
attenuate their expression and function. Cancer Res. 68:7718–7722.
2008. View Article : Google Scholar : PubMed/NCBI
|
|
12
|
Sabbir MG, Wigle N, Loewen S, et al:
Identification and characterization of Dlc1 isoforms in the mouse
and study of the biological function of a single gene trapped
isoform. BMC Biol. 8:172010. View Article : Google Scholar : PubMed/NCBI
|
|
13
|
Teramoto A, Tsukuda K, Yano M, et al: Less
frequent promoter hypermethylation of DLC-1 gene in primary
breast cancers. Oncol Rep. 12:141–144. 2004.
|
|
14
|
Syed V, Mukherjee K, Lyons-Weiler J, et
al: Identification of ATF-3, caveolin-1, DLC-1, and NM23-H2 as
putative antitumorigenic, progesterone-regulated genes for ovarian
cancer cells by gene profiling. Oncogene. 24:1774–1787. 2005.
View Article : Google Scholar : PubMed/NCBI
|
|
15
|
Chan LK, Ko FC, Sze KM, et al:
Nuclear-targeted deleted in liver cancer 1 (DLC1) is less efficient
in exerting its tumor suppressive activity both in vitro and in
vivo. PLoS One. 6:e255472011. View Article : Google Scholar : PubMed/NCBI
|
|
16
|
Hers I, Wherlock M, Homma Y, et al:
Identification of p122RhoGAP (deleted in liver cancer-1) Serine 322
as a substrate for protein kinase B and ribosomal S6 kinase in
insulin-stimulated cells. J Biol Chem. 281:4762–4770. 2006.
View Article : Google Scholar : PubMed/NCBI
|
|
17
|
Durkin ME, Yuan BZ, Zhou X, et al: DLC-1:
a Rho GTPase-activating protein and tumour suppressor. J Cell Mol
Med. 11:1185–1207. 2007. View Article : Google Scholar : PubMed/NCBI
|
|
18
|
Kim TY, Vigil D, Der CJ and Juliano RL:
Role of DLC-1, a tumor suppressor protein with RhoGAP activity, in
regulation of the cytoskeleton and cell motility. Cancer Metastasis
Rev. 28:77–83. 2009. View Article : Google Scholar : PubMed/NCBI
|
|
19
|
Hall EH, Daugherty AE, Choi CK, et al:
Tensin1 requires protein phosphatase-1alpha in addition to RhoGAP
DLC-1 to control cell polarization, migration, and invasion. J Biol
Chem. 284:34713–34722. 2009. View Article : Google Scholar : PubMed/NCBI
|
|
20
|
Liu JB, Wu XM, Cai J, et al: CpG island
methylator phenotype and Helicobacter pylori infection
associated with gastric cancer. World J Gastroenterol.
18:5129–5134. 2012.PubMed/NCBI
|
|
21
|
Wang MX, Wang HY, Zhao X, et al: Molecular
detection of B-cell neoplasms by specific DNA methylation
biomarkers. Int J Clin Exp Pathol. 3:265–279. 2010.PubMed/NCBI
|
|
22
|
Liu JB, Zhang YX, Zhou SH, et al: CpG
island methylator phenotype in plasma is associated with
hepatocellular carcinoma prognosis. World J Gastroenterol.
17:4718–4724. 2011. View Article : Google Scholar : PubMed/NCBI
|
|
23
|
Ullmannova V and Popescu NC: Expression
profile of the tumor suppressor genes DLC-1 and DLC-2 in solid
tumors. Int J Oncol. 29:1127–1132. 2006.PubMed/NCBI
|
|
24
|
Feng XL, Zhou W, Li H, et al: The DLC-1
-29A/T polymorphism is not associated with nasopharyngeal carcinoma
risk in Chinese population. Genet Test. 12:345–349. 2008.
View Article : Google Scholar : PubMed/NCBI
|
|
25
|
Calvisi DF, Pascale RM and Feo F:
Dissection of signal transduction pathways as a tool for the
development of targeted therapies of hepatocellular carcinoma. Rev
Recent Clin Trials. 2:217–236. 2007. View Article : Google Scholar : PubMed/NCBI
|
|
26
|
Yuan BZ, Jefferson AM, Baldwin KT, et al:
DLC-1 operates as a tumor suppressor gene in human non-small cell
lung carcinomas. Oncogene. 23:1405–1411. 2004. View Article : Google Scholar : PubMed/NCBI
|